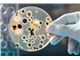
محیط کشت مرک و کیولب

محیط کشت مرک و کیولب
در خواست قیمت ارسال مشخصات مواد به شماره فکس 02189775946 ویا ارسال پیام به شماره 09362510752 درصورت نیازبه مشاوره تماس حاصل فرمایید 02166754850 02166754631 09123665197
اطلاعات تامین کننده
پارس کیمیا شیمی
تهرانوارد کننده، عمده فروش، خدمات
مواد شیمیایی، تجهیزات آزمایشگاهی، MERCK، SIGMA، FLUKA، محیط کشت، دستگاه ازمایشگاهی، انواع کیت، واردات مواد، مواد اولیه دارویی، مواد ازمایشگاهی، ازمایشگاه، HPLC، سرنگ GC، سیگما الدریچ، خرید مواد
مشاهده سایت فروشندهخرید از تامین کنندگان برتر پارس سنتر!

تامین کنندگان برتر پارس سنتر سرعت پاسخگویی بالاتر و محصولات بروز تری نسبت به سایر تامین کنندگان دارند.
مشخصات
- QLAB
- 100G
- QLAB
- 500G
- MERCK
- 500G
- BACH
- 2019
توضیحات محصول
انواع محیط کشت مرک آلمان و محیط های 100گرمی و500 گرمی کیولب.Agar Broth
انواع محیط کشت هایمدیا
انواع محیط کشت میکرومدیا و لیو
YGC AGAR/OF AGAR/PEPTON/SOYA/DGB/BGB/MALTO
پودر و گرانول
با مناسب ترین قیمت و ارسال به تمامی استان ها